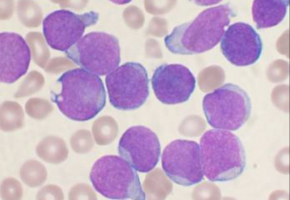
Décadas de viejo misterio en el tratamiento de la leucemia resuelto

Un equipo de investigación dirigido por la Universidad de Kent y la Universidad Goethe de Frankfurt am Main, ha resuelto un misterio de casi 40 años en la terapia de la leucemia y la droga nelarabina.
La leucemia linfoblástica aguda (LLA) es el cáncer más común en los niños.
Hay dos tipos de LLA: B-ALL, que se asemeja a los linfocitos B (células B); y T-ALL, que se asemeja a los linfocitos T (células T).
Desde la década de 1980, se sabe que la droga nelarabina es efectiva contra la T-ALL pero no contra la B-ALL, por razones que se desconocen.
El nuevo estudio de investigación revela ahora la razón y cómo esto puede cambiar los tratamientos de la leucemia; gracias a la enzima llamada SAMHD1.
La investigación muestra que SAMHD1 está presente sólo en niveles bajos en la T-ALL, en comparación con su mayor nivel de presencia en las células de la B-ALL.
Por lo tanto, SAMHD1 protege a las células B-ALL, pero no a las células T-ALL, de los efectos anticancerígenos de la nelarabina.
Los hallazgos tienen implicaciones prácticas cruciales.
Hay raros casos de B-ALL en los que las células de leucemia muestran bajos niveles de SAMHD1 y, por lo tanto, pueden beneficiarse del tratamiento con nelarabina.
Además, también hay casos de T-ALL en los que las células de leucemia tienen altos niveles de SAMHD1, que es poco probable que reaccionen a la nelarabina.
Por lo tanto, la enzima SAMHD1 es un biomarcador con el potencial de adaptar mejor el tratamiento con nelarabina a las necesidades de cada paciente con LLA.
El Dr. Mark Wass, autor del estudio de la Universidad de Kent, dijo: "Este trabajo resuelve un misterio de casi 40 años en el tratamiento de la leucemia. Los resultados podrían impactar inmensamente la efectividad de la terapia con nelarabina en particular y abrir otras puertas de entendimiento en el esfuerzo de volver a tratar esta enfermedad".
Fuente: Universidad de Kent